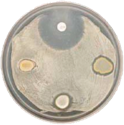

This lecture focuses on the use of microarrays in antimicrobial discovery. Microarrays can be used for transcriptional profiling, but also for genome wide fitness tests. Both methods aid in the identification of novel antibacterial modes of action.



This lecture focuses on the use of microarrays in antimicrobial discovery. Microarrays can be used for transcriptional profiling, but also for genome wide fitness tests. Both methods aid in the identification of novel antibacterial modes of action.

Lecture 1






















